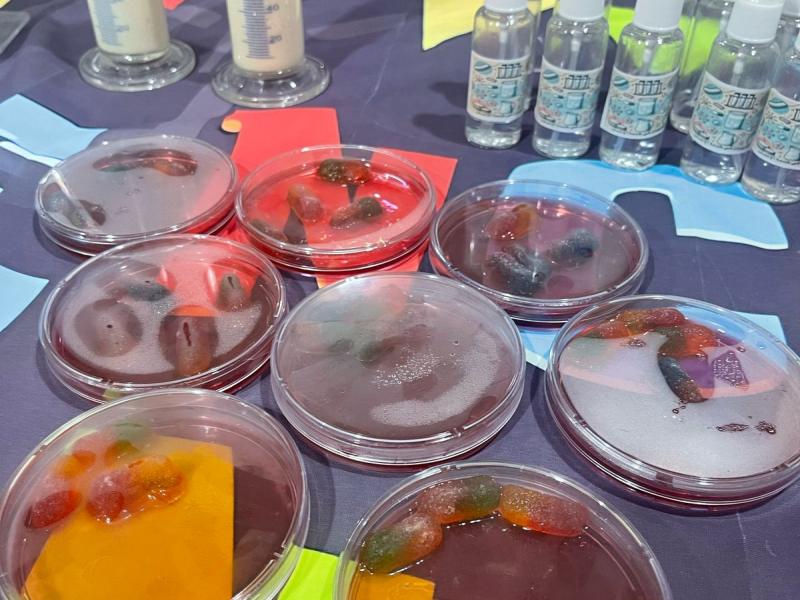

قسم الأحياء بالكلية الجامعية بالدرب يُبهر الزوار بمعرض "الميكروبات الصناعية"
13 شَعبان 1446

أقام قسم الأحياء بالكلية الجامعية بالدرب معرضًا مميزًا تحت عنوان "الميكروبات الصناعية"، والذي استقطب اهتمامًا واسعًا من الطالبات ومنسوبات الكلية على حد سواء. وقد تميز المعرض بتنوع أقسامه التي شملت: الزراعة والميكروبات، والصناعة والميكروبات، والتغذية والميكروبات، والميكروبات الطبية.
وقد هدف المعرض إلى تسليط الضوء على الدور الهام الذي تلعبه الميكروبات في حياتنا اليومية، وكيف يمكن الاستفادة منها في مختلف المجالات. ففي قسم "الزراعة والميكروبات"، تم عرض أمثلة حية لكيفية استخدام الميكروبات في تحسين خصوبة التربة ومكافحة الآفات الزراعية. وفي قسم "الصناعة والميكروبات"، تم استعراض دور الميكروبات في إنتاج العديد من المنتجات الصناعية مثل الألبان والأجبان والمخللات. أما قسم "التغذية والميكروبات"، فقد تناول أهمية الميكروبات في عملية الهضم وإنتاج بعض الفيتامينات الضرورية للجسم. وأخيرًا، عرض قسم "الميكروبات الطبية" كيف تساهم الميكروبات في إنتاج المضادات الحيوية والأدوية الأخرى التي تساعد في علاج الأمراض.
وقد أثار المعرض إعجاب الزائرات، حيث أشدن بتنوع المعروضات وبطريقة العرض الشيقة التي ساهمت في تبسيط المعلومات وجعلها في متناول الجميع.
من جانبه، أكدت رئيسة قسم الأحياء بالكلية على أهمية هذا المعرض في نشر الوعي بأهمية الميكروبات وتطبيقاتها المختلفة، مشيرًا إلى أن القسم يسعى دائمًا إلى تنظيم فعاليات مماثلة تساهم في إثراء المعرفة العلمية للطالبات ومنسوبات الكلية.
آخر الأخبار
الفعاليات
20
شَعبان
1447
شَعبان
1447
09
ذو القِعدة
1447
ذو القِعدة
1447
04
ذو القِعدة
1447
ذو القِعدة
1447